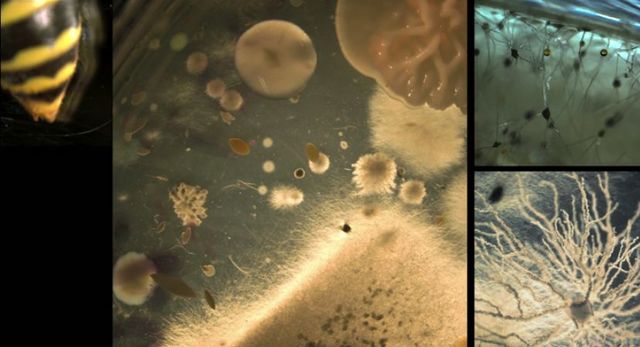
Se forma la vida microscopica

-
Solo estaba el sol rodeado de polvo, la tierra no existía,poco a poco la gravedad convierte el polvo en pequeñas rocas estas colisionaron entre sí durante muchos millones de años, constituyendo cuerpos de mayor tamaño, hasta dar origen a la tierra.
-
La temperatura asciende a 2200 °C, No hay aire, solo hay dióxido de carbono, nitrógeno y vapor caliente.
-
La tierra es una bola hirviente de roca liquida (Lava), una roca del tamaño de marte colisiona con la tierra, esto provoca una onda expansiva; con esta explosión se formo la luna de la tierra, se encontraba a 22.000 km de la tierra (mas cerca de lo normal).
-
Hace 3.900 millones de años sufrimos el ataque de los restos que quedaron de la formacion del sistema solar. Se dice que dentro de estos se encontraban pequeñas gotas de agua
-
Empiezan a aparecer vientos muy rapidos incluso mas rapidos que el huracán mas destructivo de nuestros dias. Se crea una megatormenta agitada por la rápida rotación de la tierra, la luna esta tan cerca de la tierra que su gravedad resulta apabullante (abrumador).
-
Millones de años después del nacimiento del planeta, este se encuentra lleno de agua. Surgen islas, los volcanes hacen erupción y esto provoca la formación de una isla volcánica, la lava se enfría
-
Violenta lluvia de meteoritos liberan carbono y proteínas primitivas alcanzan el fondo del océano,La temperatura del mismo era de 0°C. Se forma una ciudad submarina, se forma la vida microscópica; bacterias unicelulares.
-
En el océano profundo se formaron rocas, crecen del lecho marino estromatolitos (pirámides de bacterias) las cuales hacen los primeros procesos fotosíntesis. De este proceso natural se produce el oxigeno, el oxido se mezcla con el hierro y se forman placas ferrosas.
-
No hay formas de vida complejas, la corteza terrestre se divide en varias capas, el calor del núcleo genera movimiento y las placas se mueven.
-
Se forma el primer continente "Rodinia". El supercontinente se parte en dos, la intensa actividad geología forma volcanes que desprenden dióxido de carbono, este se mezcla con agua, se produce lluvia ácida, el dióxido se queda en las rocas.
-
El hielo se derrite, el peróxido de hidrogeno se descompone y produce grandes cantidades de oxígeno.
La tierra esta despertándose y es un lugar muy diferente. En ese momento hace 600 millones de años, la atmosfera es mas calida, como en el verano, los días duras 22 horas, si se le añade toda la cantidad de agua de la tierra es la receta perfecta para la vida. -
Hace 540 millones de años, en un océano lleno de oxígeno las bacterias primitivas han evolucionado, un puñado de ellas debió haber resistido a la gran helada
Aquí surgen las wiwaxias (genero extinto de moluscos) -
Este es uno de los periodos más dinámicos de la historia de la tierra, la explosión cámbrica, los crecientes niveles de oxigeno que permiten que las criaturas crezcan y desarrollen esqueletos óseos, hay gusanos, esponjas y trilomitos.
La vida en los océanos florece, de bacterias microscópicas a “monstruos” como el anomalocaris. En este periodo fue donde apareció un animal que le es llamado Pikaia, el cual mice 5 cm de largos pero poseen lo que podría ser la primera espina dorsal -
Las placas vuelven a moverse, por debajo se encuentra un nuevo continente, Gondwana, con una cálida temperatura de 30°. Estas tierras deberán estar cubiertas de plantas y criaturas reptadoras, pero no hay mucho.
-
El sol, cuya radiación inflama la superficie, cuando el oxígeno se topa con la radiación del sol, se forma otro tipo de gas llamado ozono, este gas forma una capa alrededor de todo el planeta, esta se espesa e impide el paso de la radiación, con esto se forma el musgo.
-
En el agua surge un pez extraño llamado Tiktaalik, su cuello le permite incorporarse en la tierra y usa sus aletas como si fueran patas para salir del agua.
-
El agua; donde la vida vegetal está en su apogeo, durante más de 15 millones de años, estas criaturas llamadas tetrápodos (rama de animales vertebrados con cuatro extremidades) evolucionan, sus extremidades se fortalecen y van pasando más y más tiempo fuera del agua, hasta que hace 360 millones de años hacen del suelo su hogar, todos los vertebrados cuadrúpedos evolucionaran
-
El hylonomus (animal pariente del lagarto) fue uno de los primeros animales en dejar sus huevos fuera del agua, ya que sus huevos contienen todo el agua y los nutrientes que las crías necesitan . El huevo es uno de los principales avances evolutivos, ahora los animales pueden dejar el agua y conquistar el continente
-
Una manada de criaturas surgen en las praderas siberianas, la evolución ha dado un paso gigante los pequeños lagartos de antes ahora son reptiles gigantes.
Son llamados Escutosaurios (reptil herbívoro) y también están los depredadores, los Gorgonoxidos, una maquina asesina prehistórica perfectamente diseñada. -
Una descomunal cantidad de lava se alza desde el interior de la tierra, el exuberante paraíso es ahora un infierno inerte, los Escutosaurios y Gorgonoxidos están muertos, son las primeras víctimas en la mayor extinción en masa que el mundo ha presenciado.
-
Hace 200 millones de años, solo existe un súper continente llamado Pangea, que se extiende de polo a polo. Después del trauma de la extinción en masa el planeta está curándose, las temperaturas se estabilizan, la lluvia acida se está neutralizando y la vegetación regresa, con el 95% de toda la vida de la tierra desaparecida el terreno está listo para el surgimiento de una nueva especie; los dinosaurios.
-
La corteza terrestre comienza a adelgazar y expulsa lava y tiembla con los terremotos como si estuviese siendo tensada por las fuerzas internas de la tierra, las placas terrestres se mueven, Pangea se rompe y se crea un nuevo océano.
-
Las placas se siguen alejando, hay nuevos continentes, nace el océano atlántico y en el medio un volcán.
Todo el lecho marino se ha partido en dos y a lo largo del mismo ha surgido una cordillera de montañas y volcanes, el agua aquí está caliente ya que la lava sale despedida del interior de la tierra, a medida que se enfría crea una nueva cordillera montañosa y un nuevo lecho oceánico eso es lo que rompe a Pangea, produce la separación de las plataformas y reconfigura nuestro mundo. -
Se aproxima un gran fragmento de roca, tiene 10 km de diámetro y viaja a más de 70 mil km/hora directo hacia la tierra. Se dirige hacia el golfo de México. Al impactar con la tierra en una fracción de segundo el mundo cambiara para siempre. En el momento del impacto el asteroide tenía una altura de casi 11 mil metros, como es tanta la fuerza con la que impacta destruye todo lo que toca, incluso el mismo asteroide se destroza en el momento
-
Los mamíferos actuales descienden de los sinápsidos primitivos, grupo de tetrápodos amniotas que comenzó a florecer a principios del Pérmico, hace unos 280 millones de años, y continuaron dominando sobre los «reptiles» terrestres hasta hace unos 245 millones de años (principios del Triásico), cuando empezaron a despuntar los primeros dinosaurios.
-
Este fin le da oportunidades a otras especies para surgir, los mamíferos ya que vivían debajo de la tierra se han salvado del fuego y del calor y al comer de todo pueden prosperar, estos evolucionan normalmente.
-
La atmosfera se parecía mucho a la de ahora, la temperatura es de 24°C y los días duran un poco menos de 24 horas.
Las placas de la tierra comienzan a moverse nuevamente con sus continentes. Las plataformas indias y asiática chocan, y ambas comienzan a levantarse, lo que una vez fue lecho oceánico se levanta a través de una línea de 2500 km, una enorme cordillera se alza: el monte Everest, del agua derretida de sus picos se forman grandes ríos, que después daran agua a casi la mitad del mundo. -
Hace 20 millones años se encuentra un simio que podría estar sentado todo el día pero como el mundo está cambiando. Las montañas que se están formando actúan como muro que no deja que la humedad penetre en el océano indico lo que produce más calor, obligando a los simios a internarse en el hábitat en busca de comida. Dejaron de restregar los nudillos y a ponerse de pie caminando en dos pies. Es el paso más importante para la humanidad.
-
Hace 1.5 millones de años, un hombre y un niño homo erectus dejan sus primeras huellas en África. La historia humana comienza aquí.
Plan projects on a visual timeline
Map milestones, phases, deadlines, and key events in one place so the sequence is easier to see and share. Timetoast is a timeline maker for work, school, research, and stories.